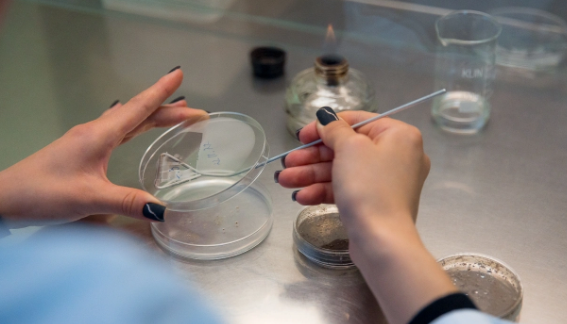

Размножается даже в холоде: инфекционный "привет" выявили в любимом продукте приморцев
Источником заражения могут быть: инфицированное сырьё, нарушение санитарных норм и технологических режимов на производстве, неправильные условия хранения
 Самое популярное за 6 часов
Самое популярное за 6 часов
